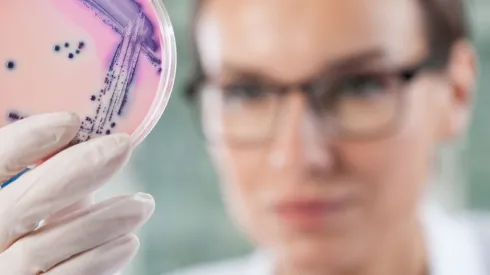
Fot. Fotolia

-

Rusza Wiki Science Competition - konkurs dla pasjonatów fotografii i nauki
Wiki Science Competition to i międzynarodowy konkurs na zdjęcia dokumentujące świat nauki. Polska edycja rozpocznie się 4 listopada i jest otwarta dla wszystkich zainteresowanych. Wszystkie fotografie zgłoszone do konkursu trafią do zbiorów Wikipedii, a najlepsze zostaną nagrodzone.
-

Startuje trzecia edycja konkursu fotograficznego „Owad w Obiektywie”
W Łodzi ruszyła trzecia edycja konkursu fotograficznego „Owad w Obiektywie”, mającego zachęcać młodych ludzi do spędzania wolnego czasu na podpatrywaniu przyrody i obserwacji owadów. Prace nadsyłać można do 2 listopada, a rozstrzygnięcie konkursu zaplanowano na grudzień.
-
Konkurs fotografii naukowej Wiki
Fotografowie nauki i naukowcy, którzy efekty, przebieg lub okoliczności swojej pracy przedstawiają na zdjęciach, mogą podzielić się swoją twórczością i do końca listopada zgłosić się do konkursu Wiki Science Competition.
-

Fotokonkurs: matematyka w obiektywie
Wartość przysłony to f/1,4, a czas naświetlania t=1/300 s. Jaki mógłby być kąt nachylenia obiektywu i moment wykonania zdjęcia? - takie pytania zadawać sobie mogą uczestnicy konkursu „Matematyka w obiektywie”. Wielbiciele matematyki i fotografii swoje zdjęcia związane z matematyką przesyłać mogą do 15 października.
-

Zimowy konkurs fotograficzny rozstrzygnięty!
Zima - przynajmniej ta astronomiczna - już się skończyła. Zakończył się także nasz zimowy konkurs fotograficzny. Dziękujemy za wszystkie nadesłane prace. Było ich w sumie 108, a wybór najlepszej okazał się naprawdę trudny.
-

Na facebooku rusza nasz zimowy konkurs fotograficzny
Szeroko pojęta zimowa przyroda - to temat kolejnej odsłony naszego facebookowego konkursu fotograficznego. Rozpoczynamy siódmą edycję zabawy, która za każdym razem cieszy się coraz większym powodzeniem odbiorców Nauki w Polsce. Tym razem na Wasze zdjęcia czekamy do 20 marca. Nagrodą dla zwycięzcy będzie nowoczesny tablet.
-

Konkurs fotograficzny - rusza nowa edycja!
Rozpoczęła się kolejna, szósta już, edycja facebookowego konkursu fotograficznego Nauki w Polsce. Tym razem tematem przewodnim jest szerokopojęta „Jesień”. Na zdjęcia czekamy do 14 grudnia 2012 r. Nagrodą dla zwycięzcy jest nowoczesny tablet.
-
Konkurs fotograficzny - czas na wyniki!
Zakończyliśmy kolejną edycję facebookowego konkursu fotograficznego serwisu Nauka w Polsce. Ta odsłona, zatytułowana „W cieniu drzewa”, była rekordowa pod względem ilości nadesłanych zdjęć.
Po przejrzeniu dziesiątek prac, jury redakcyjne zdecydowało, że nagrodę główną - tablet GOCLEVER Tab A971 - zdobywa Mariola Buta za fotografię rozłożystego drzewa nad brzegiem morza.
-
Nowy konkurs fotograficzny dla naszych fanów
Wraz z początkiem wakacji rusza kolejna, piąta już, odsłona facebookowego konkursu fotograficznego Nauki w Polsce. Tym razem jego temat brzmi: „W cieniu drzewa”. Na przesyłanie zdjęć tych cudów natury i walkę o nowoczesny tablet, który tym razem jest nagrodą dla zwycięzcy, mają Państwo czas do 15 sierpnia.
Najpopularniejsze
-

Prof. Balwicki: uzależnienie od nikotyny to choroba mózgu, a nie nawyk
-
Podkarpackie/ Profesor PRz pierwszym w historii Polakiem na czele ICLP
-
Klimatolog: pomiary w Polsce mają 200 lat; w krótkim czasie podwoiła się liczba upalnych dni
-
Badanie: kanibalizm zniknął, bo biologicznie się nie opłacał
-
Karkonosze/ Na Śnieżce odnotowano najwyższą temperaturę w historii pomiarów
-

Naukowcy odkryli, jak naprawdę powstają królowe pszczół
-
Naukowcy sprawdzili, jak depresja wpływa na ocenę rzeczywistości
-
„Economist”: AI przyniesie załamanie na rynku pracy, krach i koniec kontraktu społecznego
-
Dezinformacja o kremach z filtrem na TikToku przyciąga więcej uwagi niż rzetelne treści
-
Pająk balistyczny

















